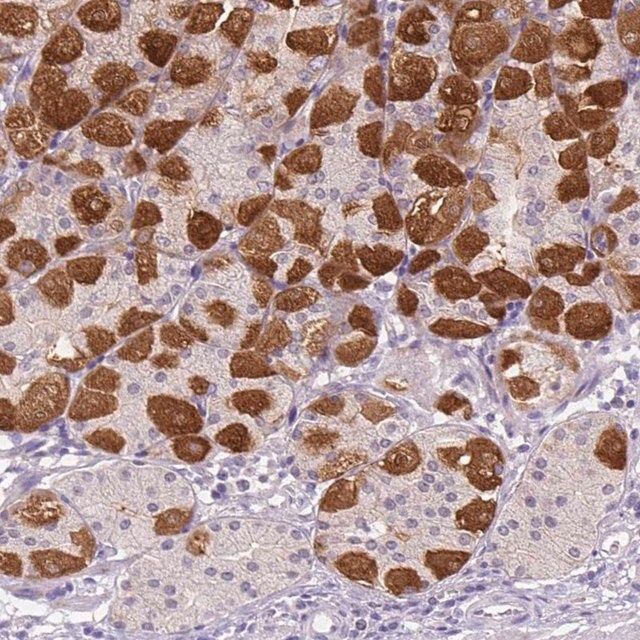

ن؛§ه“پن»‹ç»چï¼™ü/div>
ن؛§ه“پ说وکژ
ن¸€èˆ¬وڈڈè؟?/p>
Periostin, also known as PN, or Osteoblast-specific factor 2 (OSF-2), and encoded by the gene POSTN/OSF2, is a secreted extracellular matrix protein that appears to be involved in inducing cell attachment and spreading as well as cell adhesion. In bone, Periostin enhances mineralization and assists in the incorporation of BMP1 protein into the fibronectin extracellular matrix of connective tissues. Periostin is preferentially expressed in periosteum and periodontal ligaments but can also be found expressed in developing heart and other tissues. Periostin is also over expressed in many cancers where is contributes to a growth-supportive role for such cancers and also aids in chemoresistance for cancers cells through the activation of the PI3K/Akt/surviving pathway.
特ه¼‚و€?/p>
This antibody detects all splice variants of Periostin.
ه…چç–«هژü/p>
Linear peptide from the fasciclin 1 domain of mouse periostin.
ه؛”用
Research Category
Cell Structure
Anti-Periostin (Pan) Antibody is an antibody against Periostin (Pan) for use in western blotting & IHC.
Western Blotting Analysis: A representative lot detected Periostin (Pan) in mouse lung extract.
Immunohistochemistry Analysis: A representative lot detected Periostin (Pan) in certain reported tissues (Kruzynska-Frejtag, A., et al. (2004). Dev Dyn. 229(4):857-868.; Butcher, J. T., et al. (2007). Dev Biol. 302(1):256-266.; Norris, R. A., et al. (2007). J Cell Biochem. 101(3):695-711.; Inai, K., et al. (2008). Dev Biol. 315(2):383-396.; Norris, R. A., et al. (2008). Dev Biol. 316(2):200-213.).
Research Sub Category
ECM Proteins
è´¨é‡ڈ
Evaluated by Western Blotting in mouse lung tissue lysate.
Western Blotting Analysis: 1 ?g/mL of this antibody detected Periostin (Pan) in 10 ?g of mouse lung tissue lysate.
ç›®و ‡وڈڈè؟°
~75-85 kDa observed. Uniprot describes five isoforms at 93 kDa, 90 kDa, 90 kDa, 87 Kda, and 87 kDa However, this protein has been observed between 75-85 kDa
ه¤–ه½¢
Purified rabbit polyclonal in buffer containing PBS.
Affinity purified
ه‚¨هکهڈٹ稳ه®ڑو€?/p>
Stable for 1 year at 2-8،مC from date of receipt.
ه…چè´£ه£°وکژ
Unless otherwise stated in our catalog or other company documentation accompanying the product(s), our products are intended for research use only and are not to be used for any other purpose, which includes but is not limited to, unauthorized commercial uses, in vitro diagnostic uses, ex vivo or in vivo therapeutic uses or any type of consumption or application to humans or animals.
هں؛وœ¬ن؟،وپ¯
| eCl@ss |
32160702 |
| NACRES |
NA.41 |
ن؛§ه“پو€§è´¨
| ç”ں物و¥و؛گ |
rabbit |
| è´¨é‡ڈو°´ه¹³ |
100 |
| وٹ—ن½“ه½¢ه¼ڈ |
affinity isolated antibody |
| antibody product type |
primary antibodies |
| ه…‹éڑ† |
polyclonal |
| ç؛¯هŒ–و–¹ه¼ڈ |
affinity chromatography |
| species reactivity |
mouse |
| وµ“ه؛¦ |
0.5 mg/mL |
| technique(s) |
immunohistochemistry: suitable
western blot: suitable |
| NCBI登记هڈ¶ü/td> |
NP_001185694 |
| UniProt登记هڈ¶ü/td> |
Q62009 |
| è؟گ输 |
wet ice |
ه®‰ه…¨ن؟،وپ¯
| ه‚¨هکهˆ†ç±»ن»£ç پ |
10 - Combustible liquids |
| WGK |
WGK 2 |
| é—ھ点(F) |
Not applicable |
| é—ھ点(C) |
Not applicable |
 m.cnreagent.com
m.cnreagent.com